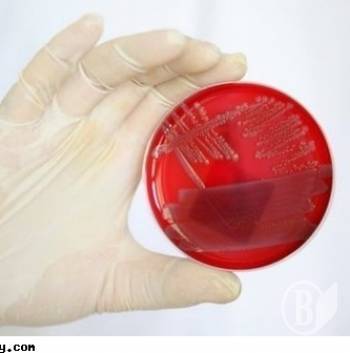
?

Холера відступила?
У засобах масової інформації в останній час з'являються повідомлення про виділення з води відкритих водоймищ холерних вібріонів не О1 групи. У багатьох людей це асоціюється з виділенням збудника, що викликає захворювання у людей на холеру. Але це не так.
Лабораторіями санепідслужби України в період з травня по жовтень проводяться моніторингові дослідження проб води із стаціонарних точок (місця масового відпочинку, водокористування, тощо). Холерні вібріони не О1 групи поширені у навколишньому середовищі, про що свідчить щорічне їх виділення з проб морської води-до 24% від кількості відібраних проб, до 30% з прісної води річок та інших водоймищ (дані по південному регіону України).
Лабораторії санепідслужби також проводять дослідження навколишнього середовища, в тому числі і води відкритих водоймищ. Тільки з травня по серпень виділено 17 культур холерного вібріону не О1групи.
Наказом №167 від 30.05.1997 р «Про удосконалення протихолерних заходів в Україні» не передбачено проведення обмежувальних заходів (заборона водокористування, закриття пляжів тощо) при виділенні холерного вібріону не О1 групи.
Слід пам'ятати, що присутність у водоймищах холерного вібріону неО1 групи передбачає розвиток у аналогічних умовах і холерного вібріону О1 і О139 який може попасти у воду від хворого на холеру і викликати захворювання у здорових людей.
Слід дотримуватись заходів з попередження захворювань, як і при будь-якій кишковій інфекції:
- дотримуватись правил особистої і суспільної гігієни;
- вживати продукти гарантованої якості, не вживати продуктів з вичерпаним терміном реалізації;
- не використовувати воду відкритих водоймищ для пиття, господарсько-побутових потреб, миття овочів, посуди на відпочинку;
- не ковтати воду при купанні пірнанні;
- купатися у спеціально відведених для цього місцях.
| Версія для друку Відправити по e-mail Обговорити на форумі |
| Переглядів : 5762 |







































Додати коментар: